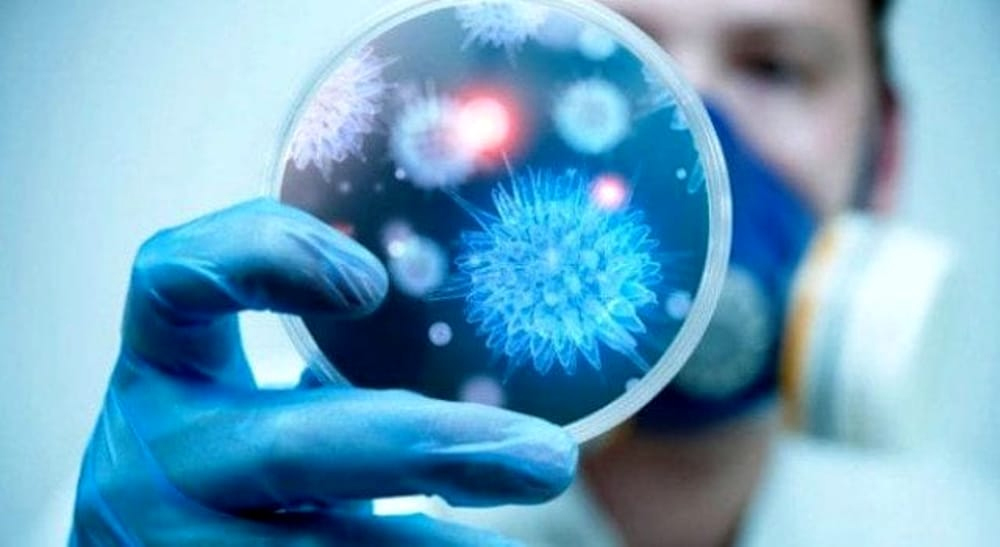
Effetto superbatteri minaccia l’economia

ROMA – Almeno 700 mila morti l’anno, tra cui 230 mila vittime della Tbc multiresistente; sempre più malattie comuni come infezioni respiratorie, urinarie, sessualmente trasmesse, che diventano incurabili; sistemi alimentari in bilico, sempre più precari. Il mondo sta già sperimentando un ‘effetto superbug’, ma un nuovo report mondiale diffuso nei giorni scorsi accende i riflettori su un rischio inedito: l’antibiotico-resistenza incontrollata non è una minaccia letale solo sul fronte salute, anche l’impatto economico sarebbe “catastrofico”.
Se non si interviene, “il danno” che si rischia “potrebbe essere paragonabile allo shock sperimentato durante la crisi finanziaria globale del 2008-2009”, denunciano le Nazioni Unite, le agenzie internazionali e un pool trasversale di esperti (Interagency Coordinating Group on Antimicrobial Resistance) creato ad hoc per analizzare il problema.
“Servono azioni urgenti”, è il messaggio, in assenza delle quali non solo “le malattie resistenti ai farmaci potrebbero arrivare a causare 10 milioni di morti l’anno entro il 2050”, ma secondo stime della Banca Mondiale “entro il 2030 fino a 24 milioni di persone potrebbero essere ridotte in condizioni di estrema povertà, principalmente nei Paesi a basso reddito”. Con una diffusione crescente degli agenti patogeni resistenti, infatti, si “impennerebbero drammaticamente le spese per l’assistenza sanitaria”, e sarebbe “sempre più a rischio una produzione alimentare sostenibile e il commercio globale di cibo, mangimi e bestiame”.
Da qui le preoccupazioni degli organismi internazionali, timori che si estendono a 360 gradi includendo anche i possibili effetti sull’ambiente e sugli ecosistemi. “La resistenza antimicrobica è una delle maggiori minacce che affrontiamo come comunità globale – avverte Amina Mohammed, Deputy Secretary-General dell’Onu e co-presidente del gruppo Iacg – Questo rapporto riflette la profondità e la portata della risposta necessaria per frenarne l’ascesa e proteggere un secolo di progressi nel campo della salute. Si sottolinea giustamente che non c’è tempo da perdere e sollecito tutte le parti ad agire e a lavorare per garantire un futuro sostenibile per tutti”.
Per scongiurare una crisi di antibiotico-resistenza potenzialmente disastrosa, spiegano gli esperti, l’azione deve essere immediata, coordinata e ambiziosa. Viene richiesto un investimento da parte dei Paesi di ogni fascia di reddito e si ribadisce l’importanza dell’approccio ‘One Health’, cioè un intervento coordinato e multisettoriale che riconosca il fatto che la salute umana, animale, alimentare e ambientale sono strettamente interconnesse.
E c’è anche una ‘road map’. Nel report vengono infatti esplicitate una serie di raccomandazioni per i Paesi: dare la priorità a piani d’azione nazionali per potenziare gli sforzi di finanziamento e rafforzamento delle capacità; istituire sistemi regolatori più rigorosi e sostenere programmi di sensibilizzazione per un uso responsabile e prudente degli antimicrobici da parte dei professionisti della salute umana, animale e vegetale; investire in ricerca ambiziosa e nello sviluppo di nuove tecnologie per combattere la resistenza antimicrobica; eliminare urgentemente l’uso di antimicrobici d’importanza cruciale come promotori della crescita in agricoltura.
Il gruppo di esperti trasversale a più agenzie Onu è stato convocato su richiesta dei leader mondiali dopo il primo meeting Onu di alto livello sulla resistenza agli antibiotici nel 2016, per formulare un piano di contrasto al fenomeno.
L’esperienza, fanno notare i promotori, rafforza l’azione collaborativa di più organismi, dall’Oms (Organizzazione mondiale della sanità) alla Fao (Organizzazione delle Nazioni Unite per l’alimentazione e l’agricoltura) e all’Oie (salute animale). “Siamo a un punto critico della lotta per proteggere alcuni dei nostri farmaci più essenziali”, conclude il direttore generale Oms e co-presidente dell’Iacg, Tedros Adhanom Ghebreyesus. “Il rapporto contiene raccomandazioni concrete che potrebbero salvare migliaia di vite ogni anno”.